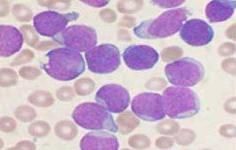
癌性發熱 癌性發熱

發病病因
現代醫學認為癌性發熱與以下因素有關:
1、惡性腫瘤生長迅速,組織相對缺血缺氧而壞死;
2、或由於治療引起腫瘤細胞大量破壞,釋放腫瘤壞死因子(TNF),導致機體發熱;
3、惡性腫瘤細胞本身可能產生內源性致熱原,如腫瘤內白細胞浸潤引起炎症反應、惡性腫瘤細胞內釋放抗原物質引起免疫反應而發熱;
4、腫瘤細胞能分泌一些活性物質,如類癌產生5-羥色胺、嗜鉻細胞瘤產生兒茶酚胺、肝癌細胞產生甲胎蛋白,以及許多腫瘤細胞能產生異位激素等,都對機體產生各種不同的反應,其中有些物質可引起發熱;
5、在腫瘤治療中放療、化療,套用干擾素、白介素Ⅱ、腫瘤壞死因子、集落刺激因子、腫瘤疫苗等製劑也可引起發熱。祖國醫學認為癌性發熱是癌症的一種常見症狀,屬於“內傷發熱”的範疇,因癌症患者病程多遷延日久、正氣不足、陰血耗損、陽氣虛衰,而致濕熱蘊遏、瘀血內結、痰濁郁伏、情志郁久不暢或因放療、化療損傷等均可導致機體陰陽氣血耗損,或陰陽氣血逆亂而成為內傷發熱;
如張介賓《景岳全書雜病謨》中記載“至若內生之熱,則有因飲食而致者,有因勞倦而致者,有因酒色而致者,有因七情而致者,有因藥餌而致者,有因過暖而致者,雖其所因不同,在內者但當察臟腑之陰陽”。癌性發熱的病因病機紛繁複雜,但總而言之不外由於人體臟腑功能衰退、氣血陰陽不足,加之以外邪乘虛而入,可見實證、虛證、虛實夾雜證三類。
鑑別診斷
一、是癌症發熱,即使高熱,有時也無特別的化驗檢查結果,而大多數疾病的發熱均伴有白細胞升高和血沉加快。
二、是癌症發熱不會覺得冷,而會覺得很熱。體溫一般在37.5-38攝氏度之間。
三、是癌症發熱時套用抗生素和抗過敏藥物無明顯作用,但套用抗癌藥物後可退燒。
四、是在不少時候,癌症發熱常為首發症狀,其後才出現腫瘤增大。因此,如果持續一段時間不退燒,應及時到醫院診斷鑑別,找出真正的病因。
癌症發熱即使高熱有時也無特別異常的化驗檢查結果,發熱持續時間較長。發熱時輕時重,每天至少有一次超過37.8℃,持續時間可達數周以上,伴有感染時可出現連續高熱,感染消除後仍會持續發熱。